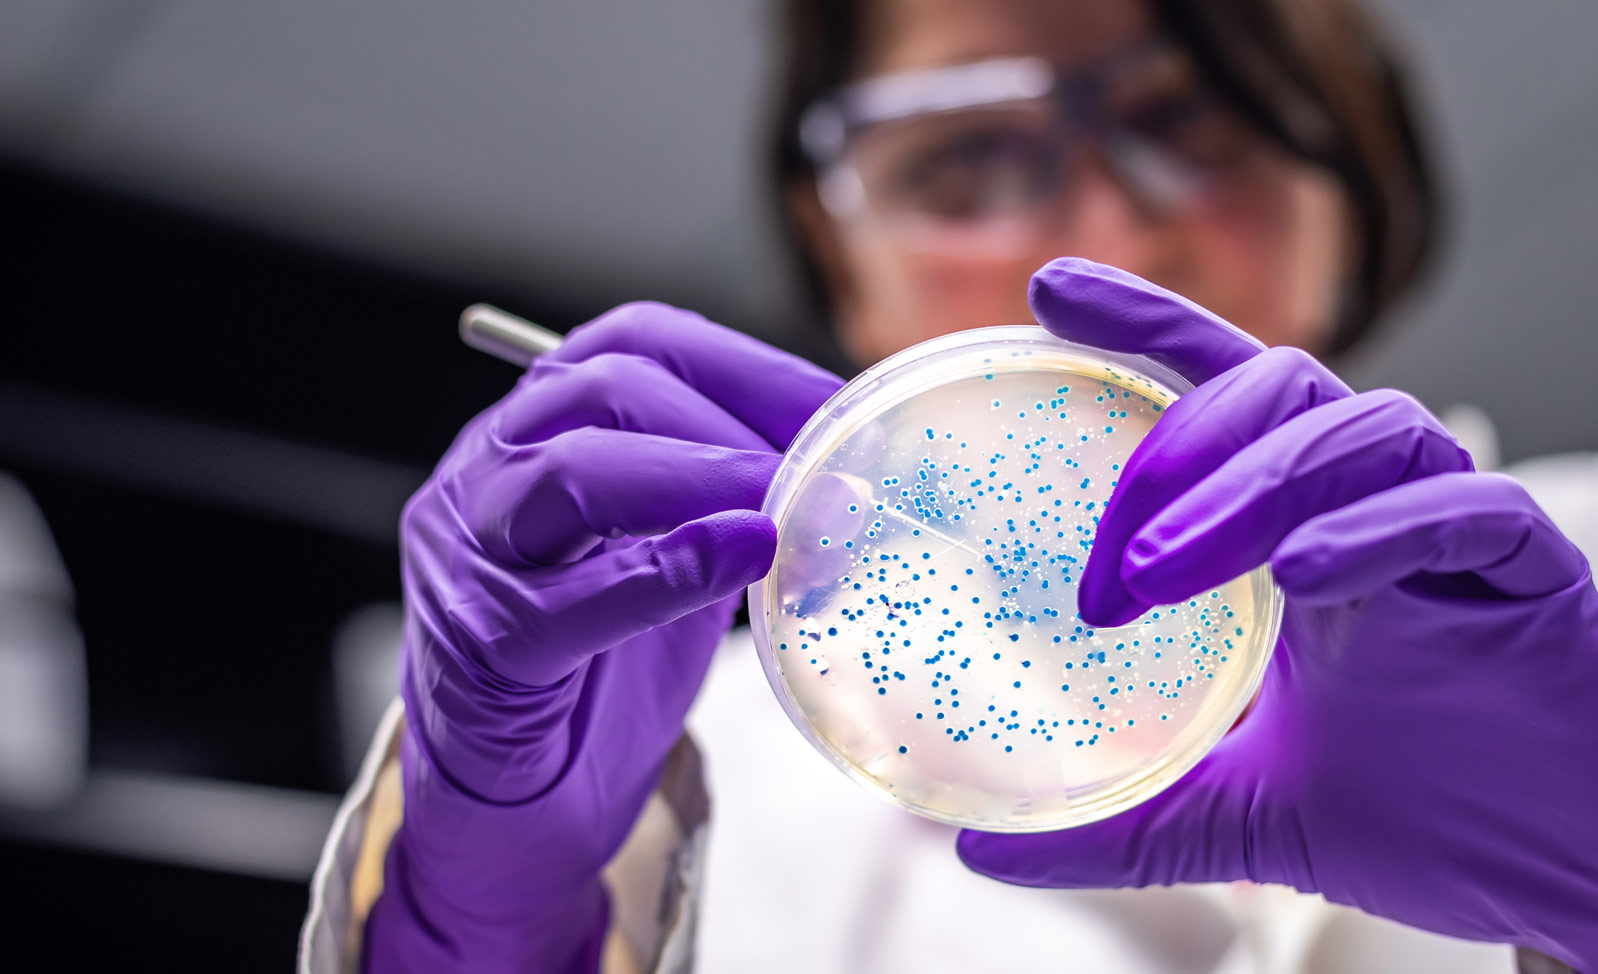
Cercetătoare cu mănuși mov examinează o cutie Petri cu bacterii în laborator

Acum părăsiți pagina Viatris România pentru un site afiliat Viatris sau un site terț care este singurul responsabil pentru conținutul său, inclusiv respectarea regulilor sale aplicabile în arii geografice specifice. Linkurile către site-urile celorlalte afiliate Viatris și site-urile terțelor părți reprezintă o resursă pentru vizitatorii noștri și pot fi guvernate de cerințe de reglementare diferite aplicabile acestui site, iar site-urile terților neafiliați sunt supuse propriilor termeni și condiții, notificări și practici privind protecția datelor. Mai mult, dacă site-ul terțului este supus legilor aplicabile altei țări, cerințele de reglementare, solicitările de protecție a datelor sau practicile medicale pot diferi între țări, iar informațiile furnizate în acesta nu pot fi utilizate în țara dvs.